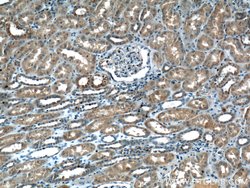
TRAF2 Rabbit anti-Human, Polyclonal, Proteintech 150 &mu;L | Buy Online | Proteintech | Fisher Scientific
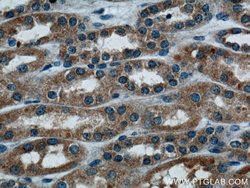
TRAF2 Rabbit anti-Human, Polyclonal, Proteintech 150 &mu;L | Buy Online | Proteintech | Fisher Scientific

missing translation for 'onlineSavingsMsg'
Learn More
Learn More
Descripción
Tumor necrosis factor (TNF) induced signaling is mediated through association of TNF receptor (TNFR) with adaptor proteins, such as TNF receptor associated proteins (TRAFs). TRAFs form a family of cytoplasmic adapter proteins that mediate signal transduction from many members of the TNF-receptor superfamily (e.g. RANK, CD30, CD40, etc.) and the interleukin-1 receptor. The carboxy-terminal region of TRAFs is required for self-association and interaction with receptor cytoplasmic domains following ligand-induced oligomerization. Recent molecular cloning studies have lead to identification of six TRAFs (TRAF1-TRAF6) (1-4). TRAF2 is a 502-amino acid protein. Mutagenic studies suggest that the N-terminal RING finger and two adjacent zinc fingers of TRAF2 are required for NF-kB activation, where as interaction with TNFR is mediated through C-terminus domain. Distinct domains in the N- and -C termini are also required for association with TRAF1 and protein kinase receptor interacting protein (RIP). TRAF2 is involved in cellular resistant to TNF-induced apoptosis. TRAF-2 deficient mice appeared normal at birth, however, they die prematurely, probably due to atrophy of thymus, spleen, muscle mass and lack of TRAF-2′s cytoprotective role.
Especificaciones
Especificaciones
| Antígeno | TRAF2 |
| Aplicaciones | Immunocytochemistry, Immunofluorescence, Immunohistochemistry (Paraffin), Western Blot |
| Clasificación | Polyclonal |
| Concentración | 0.27 mg/mL |
| Conjugado | Unconjugated |
| Formulación | PBS with 50% glycerol and 0.1% sodium azide; pH 7.3 |
| génica | TRAF2 |
| N.º de referencia del gen | Q12933 |
| Alias de gen | TRAF2, TRAP, TRAP3 |
| Símbolos de los genes | TRAF2 |
| Mostrar más |
Título del producto
Al hacer clic en Enviar, acepta que Fisher Scientific se ponga en contacto con usted en relación con los comentarios que ha proporcionado en este formulario. No compartiremos su información para ningún otro fin. Toda la información de contacto proporcionada se mantendrá de acuerdo con nuestra Política de Privacidad. Política de privacidad.
¿Detecta una oportunidad de mejora?